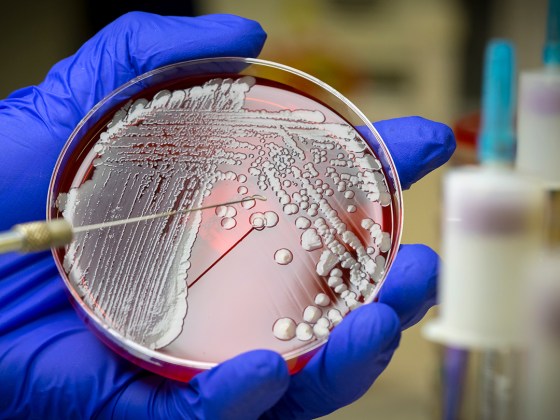

NASA

Milestones
Create a timeline of discoveries, advances and turning points that you care about most

Expanding cosmos

Dropping the bomb

Chimpanzee tools

First cloned mammal
Spotlights
Read stories of the people, projects and technologies that inspired a Century of Science
Thank You to Our Sponsors